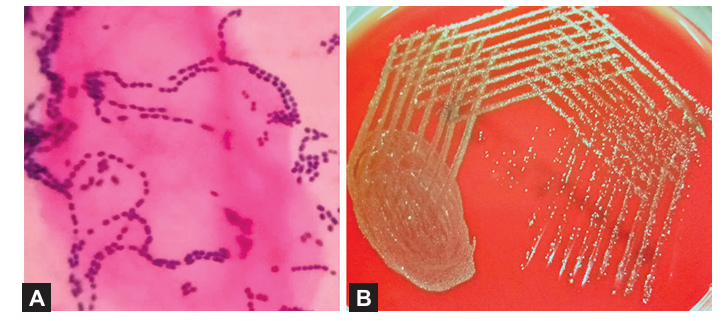

النبات
النبات
 الحيوان
الحيوان
 الأحياء المجهرية
الأحياء المجهرية
 علم الأمراض
علم الأمراض
 التقانة الإحيائية
التقانة الإحيائية
 التقنية الحيوية المكروبية
التقنية الحيوية المكروبية
 التقنية الحياتية النانوية
التقنية الحياتية النانوية
 علم الأجنة
علم الأجنة
 الأحياء الجزيئي
الأحياء الجزيئي
 علم وظائف الأعضاء
علم وظائف الأعضاء
 الغدد
الغدد
 المضادات الحيوية
المضادات الحيوية|
Read More
Date: 10-3-2016
Date: 8-3-2016
Date: 2024-12-24
|
Viridans streptococci are commensals of mouth and upper respiratory tract. Usually, they are nonpathogenic, however occasionally cause diseases such as:
- Subacute bacterial endocarditis (SABE): Viridans streptococci are the most common cause of SABE. The commensal viridans streptococci (S. sanguinis) in the oral cavity can enter blood to cause transient bacteremia while chewing, tooth brushing and dental procedures that can account for the predilection of these organisms to cause endocarditis
- Dental caries: It is mainly caused by S. mutans which breaks down dietary sucrose to acid and dextrans with the help of an enzyme glucosyl transferase. Acid damages the dentine, while adhesive dextran binds together with food debris, mucus, epithelial cells and bacteria to produce dental plaques
- In cancer patients: Viridans streptococci can cause prolonged bacteremia among neutropenic patients undergoing cancer chemotherapy
- S. milleri group (includes S. intermedius, S. anginosus, and S. constellatus): Produce suppurative infections, particularly brain abscess and empyema.
Laboratory Diagnosis
- On Gram stain, they appear as gram-positive cocci arranged in long chains (Fig. 1-A)
- They produce minute α-hemolytic green-colored (rarely non-hemolytic) colonies on blood agar (“viridis” means green, Fig. 1-B)
-They can be differentiated from Streptococcus pneumoniae (which is also α-hemolytic) by a number of tests such as resistant to optochin and insoluble in bile
- Accurate species identification is made by automated methods such as MALDI-TOF.
Fig1. viridans streptococci: a. Gram-positive cocci in long chains; B. α-hemolytic colonies on blood agar. Source: Department of Microbiology, Pondicherry Institute of Medical Sciences, Puducherry (with permission).
Treatment
They are usually sensitive to penicillin except in neutropenic patients with bacteremia, where vancomycin is the treatment of choice.



|
|
|
|
التوتر والسرطان.. علماء يحذرون من "صلة خطيرة"
|
|
|
|
|
|
|
مرآة السيارة: مدى دقة عكسها للصورة الصحيحة
|
|
|
|
|
|
|
نحو شراكة وطنية متكاملة.. الأمين العام للعتبة الحسينية يبحث مع وكيل وزارة الخارجية آفاق التعاون المؤسسي
|
|
|